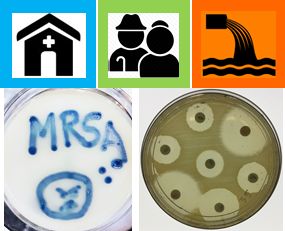

Populations in residential aged care facilities are growing rapidly. Residents in these facilities are vulnerable to the impacts of antimicrobial resistance due to resident frailty, high antibiotic usage and dense cohabitation. Antibiotic usage in aged care facilities is well-known, but data on the level, nature and spread of antimicrobial resistance, are absent. The antimicrobial resistome of samples will be determined using a novel blend of patient- plus facility- and sewage analyses. In this project we are developing new knowledge to understand the risks factors contributing to the development of antimicrobial drug resistance. The knowledge gained from this project will inform future policy decisions to mitigate these risks and to slow the spread of antimicrobial resistance in residential aged care facilities.

You must be logged in to post a comment.